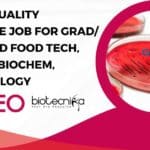
DIAGEO Quality Executive Job For Grad/Post Grad Food Tech, Biotech, Biochem, Microbiology DIAGEO Quality Executive Job
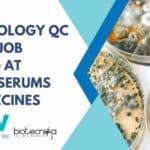
MSc Microbiology QC Officer Job Opening at Bharat Serums and Vaccines MSc Microbiology QC Officer

Home Search
biology - search results
If you're not happy with the results, please do another search
ICMR-NIIH MSc SRF Job – Biotech, Biochem, Biology, Bioinformatics, Microbio Apply Online
ICMR-NIIH MSc SRF Job - Biotech, Biochem, Biology, Bioinformatics, Microbio Apply Online
ICMR-NIIH MSc SRF Job - Biotech, Biochem, Biology, Bioinformatics, Microbio Apply Online. MSc...
CSIR-National Institute of Oceanography MSc Mol Bio, Biotech, Microbiology Project Job
CSIR-NIO Project Job Opening For MSc Mol Bio, Biotech, Microbiology
CSIR-NIO Project Job Opening For MSc Mol Bio, Biotech, Microbiology. CSIR-National Institute of Oceanography MSc...
DIAGEO Quality Executive Job For Grad/Post Grad Food Tech, Biotech, Biochem, Microbiology
DIAGEO Quality Executive Job For Grad/Post Grad Food Tech, Biotech, Biochem, Microbiology
DIAGEO Quality Executive Job For Grad/Post Grad Food Tech, Biotech, Biochem, Microbiology. BSc,...
Saint-Gobain MSc & BE Job Opening For Biotech, Microbiology
Saint-Gobain Jobs For MSc & BE For Biotech, Microbiology
Saint-Gobain Jobs For MSc & BE For Biotech, Microbiology. BE Biotechnology job, MSc microbiology job opening....
Symposium on Cell and Molecular Biology (SCMB-2023) Workshop on Biological Data Analytics | SRM...
Symposium on Cell and Molecular Biology (SCMB2023)
'Workshop on Biological Data Analytics'
Symposium on Cell and Molecular Biology (SCMB-2023) | SRM University AP & SERB
This call...
DIAGEO Research Scientist Job For Biotech, Biochem, Food Tech & Microbiology Candidates With 1-2...
DIAGEO Research Scientist Job For Biotech, Biochem, Food Tech & Microbiology Candidates With 1-2 Years Exp
DIAGEO Research Scientist Job For Biotech, Biochem, Food Tech...
Ph.D. Program in Systems Biology at Institute of Bioinformatics (IOB)
PhD Program in Systems Biology at the Institute of Bioinformatics (IOB)
Ph.D. Program in Systems Biology
Institute of Bioinformatics (IOB) is an internationally renowned interdisciplinary research...
BITS Pilani Biotech, Biochem, Mol Bio & Microbiology JRF Recruitment
BITS Pilani Mol Bio, Biotech, Biochem & Microbiology JRF Recruitment
BITS Pilani Mol Bio, Biotech, Biochem & Microbiology JRF Recruitment. B.S.-M.S./M.Sc./MTech biotechnology, life sciences, biochemistry,...
Panjab University JRF Recruitment For Biotech, Biochem, Microbiology Candidates
Panjab University JRF Recruitment For Biotech, Biochem, Microbiology Candidates
Panjab University JRF Recruitment For Biotech, Biochem, Microbiology Candidates. Candidates with MSc in Biophysics/Biochemistry/Microbiology/ Biotechnology qualifications can...
CBMR Research Associate Jobs For PhD Biotech, Life Sciences, Biology, Biochemistry
CBMR Research Associate Jobs For PhD Biotech, Life Sciences, Biology, Biochemistry
CBMR Research Associate Jobs For PhD Biotech, Life Sciences, Biology, Biochemistry. Centre of Biomedical...
IISER Pune PhD Admissions 2023 (August) – Biology PhD Programme
IISER Pune PhD 2023 Admissions (August) - Biology PhD Programme
IISER Pune PhD 2023 Admissions (August) - Biology PhD Programme. IISER Pune PhD Admission. IISER...
VIT Vellore MSc Biotech, Biochem & Microbiology JRF Recruitment, Apply Online
VIT Vellore Research Opening For MSc Biotech, Biochem & Microbiology
VIT Vellore Research Opening For MSc Biotech, Biochem & Microbiology. MSc Biochemistry, Microbiology, Biotechnology JRF...
ICMR-NIN MSc Life Sciences, Biotech, Biochem, Microbiology Project Recruitment
ICMR-NIN MSc Life Sciences, Biotech, Biochem, Microbiology Project Recruitment
ICMR-NIN MSc Life Sciences, Biotech, Biochem, Microbiology Project Recruitment. MSc Life Sciences / Biochemistry / Microbiology...
MSc Microbiology QC Officer Job Opening at Bharat Serums and Vaccines
MSc Microbiology QC Officer Job Opening at Bharat Serums and Vaccines
MSc Microbiology QC Officer Job Opening at Bharat Serums and Vaccines. BSV job opening...
SSS-NIBE Bio-Energy Promotion Fellowship For MSc, B.E., BTech Biochem, Microbiology, Biotech
SSS-NIBE Bio-Energy Promotion Fellowship For MSc, B.E., BTech Biochem, Microbiology, Biotech
SSS-NIBE Bio-Energy Promotion Fellowship For MSc, B.E., BTech Biochem, Microbiology, Biotech. Interested and eligible...